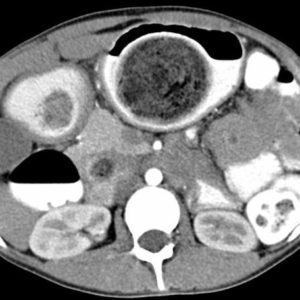
Trichobezoar
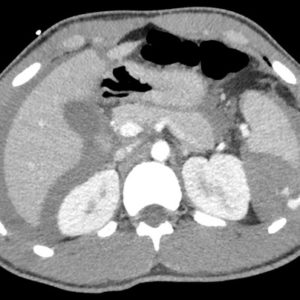
Chấn thương lách

TIÊU HOÁ
Hiển thị 1121–1140 của 1445 kết quảĐã sắp xếp theo mới nhất
-

Thoát vị hoành
Lượt xem: 209» 01-12-2018 -

Thoát vị hoành
Lượt xem: 191» 01-12-2018 -

Thoát vị hoành
Lượt xem: 170» 01-12-2018 -

Thoát vị hoành
Lượt xem: 264» 01-12-2018 -

Thoát vị hoành
Lượt xem: 386» 01-12-2018 -

Tắc ruột sỏi mật
Lượt xem: 225» 01-12-2018 -

Bezoar
Lượt xem: 261» 01-12-2018 -

Phytobezoar
Lượt xem: 241» 01-12-2018 -

Trichobezoar
Lượt xem: 293» 01-12-2018 -

Bezoar
Lượt xem: 369» 01-12-2018 -

U sau phúc mạc
Lượt xem: 552» 29-11-2018 -

Túi thừa ống tiêu hóa
Lượt xem: 449» 29-11-2018 -

Túi thừa ống tiêu hóa
Lượt xem: 175» 29-11-2018 -

U ruột non
Lượt xem: 443» 29-11-2018 -

U nhầy ruột thừa
Lượt xem: 615» 28-11-2018 -

Nang sán chó
Lượt xem: 393» 28-11-2018 -

Chấn thương gan
Lượt xem: 446» 28-11-2018 -

Chấn thương gan
Lượt xem: 406» 28-11-2018 -

Chấn thương lách
Lượt xem: 10064» 27-11-2018 -

Chấn thương lách
Lượt xem: 431» 27-11-2018